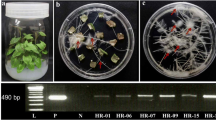

Abstract
Bioreactor cultures have been used for biomass production and bioactive compounds accumulation in adventitious root cultures of medicinal plants. In this study, we evaluated the effects of different auxin types [indole-3-butyric acid (IBA) and 1-naphthaleneacetic acid (NAA)] and concentrations (0.5, 1.0, 2.0 and 4.0 mg·L−1), Murashige and Skoog (MS) medium salt strength (0.25, 0.5, 0.75, 1.0, 1.5 and 2X), and sucrose concentrations (0, 1.5, 3, 5, 7 and 10%) on Polygonum multiflorum Thunb. adventitious root cultures in a 3-L balloon-type bubble bioreactor (BTBB). IBA (1, 2, and 4 mg·L−1) was more effective than NAA in promoting root growth. Additionally, low MS salt strength (0.25 and 0.5X MS) increased the accumulation of total phenolics and flavonoids but reduced biomass accumulation. Four weeks of culture in full-strength MS medium supplemented with 2 mg·L−1 IBA and 5% sucrose resulted in the highest root biomass [98.46 g·L−1 fresh weight (FW); 13.46 g·L−1 dry weight (DW)] and bioactive compounds accumulation (total phenolics compounds, 53.08 mg·g−1 DW; total flavonoids, 25.10 mg·g−1 DW). To determine whether metabolic fingerprinting of whole-cell extracts could be used to compare metabolic equivalence of P. multiflorum root samples, we treated adventitious roots with different culture conditions, and analyzed the treated adventitious roots and natural roots by Fourier transform infrared (FT-IR) spectroscopy. The results showed that the metabolic pattern of adventitious root samples was similar under different culture conditions; however, these samples could be discriminated from each other in pilot-scale bioreactors. Overall, our study provides useful information for industrial-scale cultivation of P. multiflorum adventitious roots.
Key message
The optimum condition for bioreactor culture of Polygonum multiflorum is full-strength MS medium supplemented with 2 mg·L-1 IBA and 5% sucrose after 4 weeks of culture. FT-IR analysis can rapidly discriminate among root samples based on total metabolite equivalence.
Similar content being viewed by others
Explore related subjects
Discover the latest articles, news and stories from top researchers in related subjects.Avoid common mistakes on your manuscript.
Introduction
With more than 8000 structures currently known, phenolic compounds are the most abundant secondary metabolites of plants; they are ranging from simple molecules such as phenolic acids to highly polymerized substances such as tannins (Dai and Mumper 2010; Liu et al. 2018; Ho et al. 2019a). Polygonum multiflorum Thunb., an important medicinal herb of Southeast Asia, have been characterized for the content of phenolic compounds including stilbenes, flavonoids, tannin, anthraquinones, and phospholipids, which are responsible for their pharmaceutical and antioxidant properties (Lishuang et al. 2014; Ho et al. 2019a). Various studies have also indicated a much wider role for bioactive compounds of P. multiflorum as anti-cancer, anti-inflammatory, anti-aging, anti-diabetic, anti-microbial, and anti-oxidant (Bounda and Feng 2015). The root extracts of this herb were traditionally used for the treatment of coronary heart disease, hyperlipidemia, neurosis (Wu et al. 2012), hair dye, baldness and hair loss, potent liver and kidney tonic (Han et al. 2015; Liu et al. 2018), and potential prophylactic use for reducing adiposity (Choi et al. 2018). Besides that, chemical constituent, processing mechanism, quality evaluation, and their biological activities have been widely discussed in the previous studies (Thiruvengadam et al. 2014; Ho et al. 2018a, 2019a; Liu et al. 2018). Recently, the rising demand for this plant led to overexploitation of natural habitat; but the content of bioactive compounds in P. multiflorum roots is unstable in the natural environment. Low yields, slow growth cycles, and fluctuations in quality and quantity due to adverse environmental, seasonal, and geographical conditions are several drawbacks by field cultivation (Ho et al. 2019a). Therefore, alternative systems for production of bioactive compounds are extremely important for P. multiflorum root cultures.
Plant cells, tissues, and organs cultures are useful research tools and objects of plant developmental biology (Fehér 2019). The recent advance in adventitious roots, hairy roots, callus, somatic embryogenesis culture, and mass multiplication of medicinal plants represents the best alternative to conventional methods for increasing the yields of bioactive compounds while helping to conserve plant bioresources in their natural habitat (Park and Paek 2014; Nhut et al. 2015). Adventitious roots are attractive sources of phytochemicals, including phenolic compounds, owing to their rapid growth and genetic and biosynthetic stability (Chandra and Chandra 2011; Murthy et al. 2014). They have been successfully used for biomass and bioactive compounds production in numerous medicinal plants such as Oplopanax elatus (Jiang et al. 2015, 2017), Panax ginseng (Paek et al. 2009), Withania somnifera (Praveen and Murthy 2012), Panax vietnamensis (Tam et al. 2013), and Eleutherococcus koreanum (Lee et al. 2015). In case of P. multiflorum, there have several studies on hairy root (Thiruvengadam et al. 2014; Ho et al. 2018b) and adventitious root (Ho et al. 2017, 2018a, 2019b) culture to produce of biomass and bioactive compounds. However, further optimization of culture conditions are needed for the propagation and multiplication in adventitious root of P. multiflorum.
In addition, the main concern in the field of phytochemical production from the cell or root cultures is converting laboratory-scale research to large-scale production (Paek et al. 2009; Baque et al. 2012a; Murthy et al. 2014). Airlift bioreactors appear to be ideal for plant cell and organ cultures, and are suitable for the cultivation of hairy and adventitious roots of various medicinal plants (Murthy et al. 2014, 2016). Compared with bulb-, cone-, and cylinder-type bioreactors, balloon-type bubble bioreactor (BTBB) is the most suitable for large-scale production of biomass and ginsenosides from adventitious root and cell culture of Panax ginseng (Kim et al. 2004; Thanh et al. 2014) and other medicinal plants (Baque et al. 2012a; Cui et al. 2013; Murthy et al. 2016). BTBB provides optimum conditions for root growth and bioactive compounds accumulation by efficiently controlling the culture conditions, foam generation, shear stress, and oxygen supply (Baque et al. 2012a; Murthy et al. 2016).
Furthermore, by the simplicity and speed of sample preparation and analysis, Fourier transformation infrared (FT-IR) spectroscopy combines with multivariate analysis have been used to rapidly discriminate of metabolic equivalent in herbal medicine resources (Kwon et al. 2014; Kim et al. 2015). Although the previous research indicated that FT-IR spectroscopic analysis enabled discrimination in metabolites accumulation between hairy root and adventitious root cultures in P. multiflorum (Ho et al. 2018b), no study has reported for discriminated adventitious root cultivated under different culture conditions and in pilot-scale bioreactors. Hence, the current study was carried out not only used a BTBB to optimize the culture conditions (auxin concentration, salt strength, and sucrose concentration) for maximizing the production of biomass and bioactive compounds (phenolics and flavonoids); but also used FT-IR spectroscopy to rapidly determine their metabolite equivalence in whole-cell extracts prepared from various adventitious root sources of P. multiflorum (Table 1).
Materials and methods
Adventitious root culture
Adventitious root cultures of Polygonum multiflorum Thunb., which were induced in Floriculture and Biotechnology laboratory, Chungbuk National University, Republic of Korea, were maintained in liquid MS medium (Murashige and Skoog 1962) supplemented with 4.92 µM indole-3-butyric acid (IBA) and 3% sucrose. Cultures were grown at 24 ± 1 °C under dark conditions in a BTBB, an air-lift bioreactor (Fig. 1), and subcultured regularly at 4-week intervals.
Adventitious root culture in an air-lift bioreactor. A Schematic diagram of a balloon-type bubble bioreactor (BTBB). (a) air compressor, (b) air flow meter, (c) membrane filter, (d) glass sparger, (e) medium sampling port, (f) Rubber cap. Arrows indicate air flow. B Adventitious root culture of Polygonum multiflorum in BTBB
Optimization of culture conditions
To optimize the culture conditions, adventitious roots of P. multiflorum were cultivated for 4 weeks in a 3-L BTBB (Fig. 1) containing 2 L of MS medium (initial pH = 5.7–5.8) at different auxin concentrations (0.5, 1.0, 2.0, and 4.0 mg·L−1 of IBA or 1-naphthalene acetic acid [NAA]). The MS medium at different strengths (0.25, 0.5, 0.75, 1.0, 1.5, and 2.0Χ) and sucrose concentrations (0%, 1.5%, 3%, 5%, 7%, and 10%) were also applied. Experiments were performed in sequence in the dark at 24 ± 1ºC and 0.1 vvm (air volume flow per unit of culture volume per minute) dissolved oxygen.
Determination of root biomass
After 4 weeks of culture, roots were harvested and washed with distilled water. The fresh weight (FW) of roots was measured after removing excess surface water with a tissue paper, and dry weight (DW) of roots was recorded after drying the roots to a constant weight at 60 °C for 48 h. The growth index (GI) and overall productivity (P) were calculated as follows:
where, the final and initial DW are estimated in grams; P is estimated in mg·L−1 (w/v); metabolic yield is estimated as mg·g−1 root DW; volumetric root biomass yield is estimated as g·L−1 DW.
Determination of total phenolic and flavonoid contents
Preparation of root extract
The root extractions were prepared according to the reports of Ho et al. (2017, 2019b). Dried roots (0.5 g) were refluxed (LS-2050-S10, LS-TECH, Korea) with 15 mL of 80% methanol at 80 °C for 1 h. Samples were then filtered through a filter paper (Advantec 110 mm, Toyo Rosihi Kaisha Ltd., Tokyo, Japan).
Determination of total phenolic content (TPC)
TPC was analyzed spectrophotometrically from the root ethanolic extract using the Folin-Ciocalteu colorimetric method (Wu et al. 2006). Methanolic extracts (0.05 mL) were mixed with 2.55 mL of distilled water. Then, 0.1 mL of 2 N Folin-Ciocalteu reagent was added to each sample. After 5 min, 20% Na2CO3 (0.5 mL) was added and thoroughly mixed. The reactions were incubated in the dark at room temperature. Color change was recorded after 30 min by measuring the absorbance at 760 nm using a spectrophotometer (Optizen POP, Mecasys Co., Ltd, Daejeon, Korea). The measurements were compared with a standard curve obtained for gallic acid (Sigma Chemical Co., St. Louis, MO, USA) and expressed as mg gallic acid equivalent (GAE) per g DW adventitious roots.
Determination of total flavonoid content (TFC)
TFC was determined colorimetrically according to the method of Wu et al. (2006). Methanolic root extracts and (+)-catechin (Sigma Chemical Co.) standard (0.25 mL) were mixed with 1.25 mL of distilled water. Then, 0.075 mL of 5% NaNO2 was added to each sample and shaken vigorously. After 6 min, 0.15 mL of 10% AlCl3 was added, and the sample was incubated at room temperature for 5 min. Absorbance was measured at 510 nm using a spectrophotometer (Optizen POP, Mecasys Co., Ltd, Korea). The results were expressed as mg (+)-catechin equivalents per g DW adventitious roots.
FT-IR analysis
The method for FT-IR spectroscopy analysis, processing of spectral data, and multivariate analysis were carried out as described previously by Ho et al. (2018b). In this study, samples from various adventitious root sources of P. multiflorum were used to rapidly determine their metabolite equivalence in whole-cell extracts. Besides the samples in the current work, the other samples were done in the condition at the previous studies of Ho et al. 2017, and 2018a were also collected (list at Table 1). After grinding the dried roots, 20 mg of root powder was combined with 200 µL of 20% (v/v) methanol in a 1.5 mL microfuge tube and mixed vigorously for extraction. A Tensor 27 FT-IR spectrometer (Bruker Optics GmbH, Ettlingen, Germany), equipped with a deuterated triglycine sulfate (DTGS) detector, was used for infrared measurements. The pre-processed FT-IR spectral data after a second differentiation were imported into the R statistical analysis program (version 2.15.0; R Development Core Team) for pre-processing the spectra of the data baseline correction, normalization, and mean centering of the FT-IR spectra. PCA and PLS-DA were performed using the R program (Ho et al. 2018b).
Statistical analysis
The experiment was conducted in a completely randomized design, with at least three replicates. Significant differences were determined by Duncan’s multiple range test using the SAS software (version 9.4; SAS Institute, USA).
Results and Discussion
Effect of IBA and NAA on adventitious root growth and bioactive compounds production
Adventitious root growth
Optimum auxin concentration is critical for root growth and bioactive compounds accumulation in adventitious root cultures. To determine the optimum type and concentration of auxin required for P. multiflorum adventitious root cultures, we supplemented the MS medium with different concentrations of IBA or NAA. The highest FW (80.48 g·L−1), DW (10.12 g·L−1), and GI (19.25) were obtained with 2 mg·L−1 of IBA, meanwhile the highest percent DW (18.69%) was observed with 0.5 mg·L−1 of IBA, (Table 2; Fig. S1). IBA was more effective than NAA for later root induction and root growth. IBA produced numerous slender and elongated roots, whereas NAA produced short and thick roots (Fig. S1). Selection of the auxin type and concentration affected root differentiation or dedifferentiation, root biomass, and bioactive compounds production. In the absence of exogenous phytohormone supply, root explants show no growth (Zhang et al. 2012). The positive and negative effects of IBA and NAA, respectively, on adventitious root induction and growth in P. multiflorum are consistent with previous studies (Martinez-Bonfil et al. 2014; Ghimire et al. 2018; Zhang et al. 2020; Zhao et al. 2020).
Phenolic compounds production
IBA significantly increased the TPC of P. multiflorum adventitious root culture (p ≤ 0.05) but did not affect the TFC (Fig. 2). The highest contents of phenolics and flavonoids (44.99 and 21.34 mg g−1 DW, respectively) were obtained at 2 mg L−1 IBA (Fig. 2a, b). The productivity of bioactive compounds in the bioreactor culture was calculated based on root DW. MS medium supplemented with 2 mg L−1 IBA showed the highest productivity of both total phenolics (455.29 mg L−1 medium) and total flavonoids (215.92 mg L−1 medium). Auxins in the culture medium have a major impact on the growth, multiplication, and metabolic activities of adventitious roots (Murthy et al. 2016; Zhao et al. 2020). Previously, medium supplemented with IBA or NAA was established for comparing growth and bioactive compounds in Panax gingseng (Jeong et al. 2009), Morinda citrifolia (Baque et al. 2012a), Eurycoma logifolia (Lulu et al. 2015); Panax notoginseng (Zhao et al. 2020); these studies also showed that IBA was flavor for root biomass and bioactive compounds accumulation. Tam et al. (2013) showed that IBA (5 mg L−1) was more effective than NAA and indole-3-acetic acid (IAA) in increasing the growth and ginsenoside content of Panax vietnamensis adventitious root culture. Our results indicated that 2 mg L−1 IBA was suitable for biomass production and bioactive compounds accumulation in the bioreactor system of P. multiflorum adventitious root cultures.
Effect of IBA and NAA on bioactive compound accumulation in adventitious root cultures of P. multiflorum after 4 weeks. a Total phenolic content (TPC). b Total flavonoid content (TFC). c, d Productivity of total phenols (c) and total flavonoids (d). Data represent mean ± standard error (SE; n = 3). Different lowercase letters in each graph indicate significant differences (p ≤ 0.05; Duncan’s multiple range test)
Effect of MS medium salt strength on adventitious root growth and bioactive compounds accumulation
Adventitious root growth
Salt strength of the growth medium such as MS (Murashige and Skoog 1962), Gamborg B5 (Gamborg et al. 1968), LS (Linsmaier and Skoog 1965), and SH (Schenk and Hildebrandt 1972) has a major impact on biomass production and secondary metabolites accumulation in plant cell and organ cultures of several plant species (Murthy et al. 2016). For example, half-strength MS medium is effective in increasing the biomass and bioactive compounds content of adventitious roots of M. citrifolia in a bioreactor culture (Baque et al. 2013). Tam et al. (2015) showed that the SH medium is suitable for adventitious root culture of Panax vietnamensis. In Panax ginseng, both half- and full-strength MS media increased the production of adventitious roots, whereas full-strength MS medium maximized the ginsenoside content (Yu et al. 2000). In this study, salt strength of the MS medium significantly affected biomass and bioactive compounds production in P. multiflorum adventitious root culture. The FW, DW, and GI of P. multiflorum adventitious root culture increased with the increase in MS salt concentration up to full-strength MS, and decreased thereafter (Table 3; Fig. S2). The FW of adventitious root cultures showed no significant differences at MS salt concentrations ranging from 0.75–2X. Notably, the highest FW (87.56 g·L−1), DW (10.92 g·L−1), %DW (12.48%), and GI (20.83) of P. multiflorum adventitious root cultures were achieved at full-strength MS medium (p ≤ 0.05). In vitro cultures of plant cells, tissues, and organs consume water and minerals from the culture media to maintain growth and development (Murthy et al. 2016). Salt strength of the MS medium affects water potential, which affects the uptake of water and nutrients by the adventitious roots (Baque et al. 2010; Zhang et al. 2020). In this study, MS salt strength greater than 1X may decrease the water potential, which inhibited the absorption of water and mineral nutrients from the culture medium, thus inhibiting root growth. By contrast, at low salt strength, especially 0.25X MS, the adventitious root culture showed no increase in biomass production because of the lack of nutrients required for anabolism (Cui et al. 2010; Lee and Paek 2012).
Phenolic compounds production
MS medium salt strength affected not only the biomass of P. multiflorum adventitious root cultures but also bioactive compounds accumulation in these cultures (Fig. 3). The highest TPC (56.24 mg·g−1 DW) were observed at the lowest salt strength (0.25X) and tended to decrease with increase in salt strength, while the TFC presented an insignificant difference in 0.25X up to 1,0X MS. Previous studies reported that the effect of salt strength on the highest root biomass and highest bioactive compounds accumulation in adventitious root culture were differed in various plant species. For example, Cui et al. (2010) showed that full-strength MS was optimal for biomass production; however, the highest TPC and TFC were recorded at 0.25X MS in Hypericum perforatum. In bioreactor culture of M. citrifolia, adventitious roots showed the highest biomass at 0.5X MS, whereas highest content of bioactive compounds was obtained at 1.5X MS (Baque et al. 2013). Therefore, to determine the MS salt strength optimal for both biomass and bioactive compounds production, we calculated the total productivity of bioactive compounds (mg·L−1). Previous studies showed that 0.5X MS medium was suitable for biomass and metabolite production in adventitious root cultures of Echinacea angustifolia (Wu et al. 2006), Eleutherococcus koreanum (Lee and Paek 2012), and M. citrifolia (Baque et al. 2013). Whereas the highest ginsenosides accumulation was achieved at 0.5X MS medium without NH4NO3 in P. notoginseng (Zhao et al. 2020). These results suggested that low salt strength improves the interaction among nutrients in the medium, causing an enhanced supply of ions to root. On the other hand, high salt strength strongly inhibited root biomass and deleterious effect on the bioactive compounds production (Ghimire et al. 2018). However, in the present study, the highest productivity of bioactive compounds was achieved at full-strength MS medium (TPC, 548.61 mg·g−1 DW; TFC, 227.96 mg·g−1 DW). This is consistent with a previous study, the highest biomass and withanolide-A accumulation on Withania somnifera, biomass and celastrol accumulation on Tripterygium wilfordii were resulted in full-strength MS (Praveen and Murthy 2012; Zhang et al. 2020, respectively). Our results suggest that full-strength MS medium is the most effective for adventitious root culture in P. multiflorum.
Effect of MS medium salt strength on bioactive compound production in adventitious root cultures of P. multiflorum after 4 weeks. a Content of bioactive compounds (mg·g−1 DW). b Productivity of bioactive compounds (mg·L−1 medium). Data represent mean ± SE (n = 3). Different lowercase letters in each graph indicate significant differences (p ≤ 0.05; Duncan’s multiple range test)
Effect of sucrose concentration on adventitious root growth and bioactive compounds production
Adventitious root growth
The type and concentration of carbon substrates supplied to the plant material during in vitro culture affect its growth, development, and secondary metabolite yield (Murthy et al. 2014). In comparison with other sugars (glucose, fructose, and maltose), sucrose is the most effective for the growth of adventitious root and hairy root cultures (Praveen and Murthy 2012; Shilpha et al. 2015; Murthy et al. 2016). In this study, the effect of various sucrose concentrations (0%, 1.5%, 3%, 7%, and 10%) was tested on root biomass and bioactive compounds accumulation in P. multiflorum adventitious root culture after 4 weeks. Sucrose concentrations of up to 5% had a positive effect on root biomass (Table 4; Fig. S3). The maximum FW (98.46 g·L−1), DW (13.46 g·L−1), and GI (25.91) were reached at 5% sucrose (p ≤ 0.05). The vigorus root growth related to the more sucrose consumer. However, the increase of sucrose concentration led to increase of the osmolarity of culture media, which was the reason for dehydration and promotes the diffusion of metabolites from tissues into media, could cause the loss of cell viability, reduced growth, modified the root morphology, and inhibited lateral branching (Thiruvengadam et al. 2014; Jiao et al. 2015; Murthy et al. 2016). The current study was also showed that root biomass of P. multiflorum decreased dramatically upon a further increase in initial sucrose concentration to 7% or 10%. By contrast, roots did not grow and die thereafter in the culture medium without sucrose (0%) (Table 4).
Phenolic compounds production
Similar to root biomass, the TPC and TFC of P. multiflorum adventitious root cultures were significantly affected (p ≤ 0.05) by the initial sucrose concentration (Fig. 4). The highest TPC (53.08 mg·g−1 DW) and TFC (25.10 mg·g−1 DW) were achieved at 5% sucrose. In addition, significantly higher productivity of total phenolics and flavonoids was observed at 5% sucrose (714.39 and 337.79 mg·L−1 medium, respectively). Recently, in addition to proving energy, sucrose has been recognized as a signaling molecule that affects the growth, development, and metabolism of in vitro plant cultures (Praveen and Murthy 2012; Murthy et al. 2014; Zhao et al. 2020). The sucrose-specific regulation of biosynthesis of various bioactive compounds such as saponin, anthocyanin, phenolics, flavonoids, anthraquinone, etc., have previous been reported (Baque et al. 2012a, b). Generally, 3% sucrose is used for the growth and development of plant cell and organ cultures (Murthy et al. 2014; Shilpha et al. 2015; Yoon et al. 2015). However, an increase in bioactive compounds accumulation is observed at higher sucrose concentrations, possibly because of higher osmotic stress at these concentrations (Cui et al. 2010; Baque et al. 2012b). The osmotic stress is responsible for the induction of reactive oxygen species (ROS), which is subsequently responsible for inducing of signal transduction, genes expression, followed by the accumulation of bioactive compounds. Sucrose concentrations of 5% and 7% led to the highest accumulation of biomass and metabolites in adventitious roots of Echinacea angustifolia (Wu et al. 2006). Paek et al. (2009) observed that 5% initial sucrose concentration was suitable for biomass and ginsenoside production in the bioreactor culture of P. ginseng adventitious roots. Meanwhile, the total yield of three ginsenosides (Rg1, Re and Rb1) was highest in root cultures with 3% sucrose in Panax notoginseng (Zhao et al. 2020). The ability to absorb and process carbon source metabolism varies depend on each plant species; in the present study, the highest root biomass and bioactive compounds accumulation were achieved at 5% sucrose concentration, indicating that 5% sucrose is suitable for P. multiflorum adventitious root culture in a bioreactor.
Effect of sucrose concentration on bioactive compound production in P. multiflorum adventitious root cultures. a Content of bioactive compounds. b Productivity of bioactive compounds. Data represent mean ± SE (n = 3). Different lowercase letters in each graph indicate significant differences (p ≤ 0.05; Duncan’s multiple range test)
Rapid discrimination among adventitious root in various culture condition sources based on FT-IR spectroscopy and multivariate analysis
Owing to its simplicity and speed of sample preparation and analysis, FT-IR spectroscopy has been used to evaluate whole-cell extracts (Kim et al. 2009; Kwon et al. 2014; Song et al. 2016). In this study, FT-IR spectroscopy, followed by multivariate analysis, was used to discriminate among adventitious root cultures of P. multiflorum based on metabolic equivalence (Table 1). Comparison of FT-IR spectra of various samples showed the biggest differences within the ranges of 1500–1700 cm−1 (region of amino acids and proteins including amides I and II), 1300–1500 cm−1 (region of phosphodiester group of nucleic acids and phospholipids), 900–1200 cm−1 (region of carbohydrates including monosaccharides and polysaccharides) (Fig. 5a). PCA showed that PC1 and PC2 explained 16.0% and 11.9% (total 27.9%) of the variation, respectively (Fig. 5b). The FT-IR data of most of the adventitious root samples overlapped with each other; however, only the natural root was classified. These results suggested that the qualitative and quantitative patterns of FT-IR spectra-based metabolites of whole-cell extracts were very similar across adventitious root samples grown under different culture conditions. Previously, Ho et al. (2018b) showed significant variation in adventitious root and hairy root cultures of P. multiflorum within the 800–850 cm−1 region, which reflect the structure of polyphenol molecules containing a CH ring (Schulz and Baranska 2007). However, in this study, the results of PCA loading value analysis showed the biggest difference within the FT-IR spectral ranges of 1500–1700 cm−1 and 900–1200 cm−1 (Fig. 5c). This implies that regions of amino acids, proteins (including amides I and II), and carbohydrates played an important role in the discrimination among P. multifolorum adventitious root samples. Consistent with our results, Kwon et al. (2014) reported that the polysaccharide (1050–1150 cm−1) and protein amide (1550–1650 cm−1) regions are important for discriminating among adventitious root cultures derived from different ages and types of ginseng cultivars.
Representative FT-IR spectra of P. multiflorum root samples. a Two-dimensional PCA scores. Each line represents the FT-IR spectra of an adventitious root sample cultured under different conditions. b Loading values of PCA plot. c PCA scores. d PLS-DA score plot. Dotted ellipses represent clusters of P. multiflorum root samples. P, ex vitro root; P1–P11, Adventitious root samples grown in different culture conditions (listed in Table 1)
Furthermore, P. multiflorum samples could be distinguished more clearly using PLS-DA than using PCA (Fig. 5d). Ex vitro root samples are distributed on the left side of the PLS-DA score plot, whereas all adventitious root samples are distributed on the right side. In contrast to PCA results, PLS-DA results showed that adventitious root samples formed a separate group at the bottom of the plot. PLS-DA analysis of the FT-IR spectral data showed that all 11 P. multiflorum root samples clustered into three major groups. The first group consisted of ex vitro root samples; the second group consisted of adventitious root samples grown in a 500-L tank bioreactor; and the third group consisted of adventitious root samples treated with sucrose (3% and 5%) and elicitors (50 and 100 µM MeJA; 50 and 100 µM SA), and those grown in a flask (0.25-L), 5-L bioreactor, and 20-L bioreactor. Kim et al. (2009) showed that PLS-DA results in discrete clusters in cultivation strawberry leaves and fruits. Similarly, Song et al. (2016) showed that PLS-DA separated five Citrus lines into three distinct clusters. The results of the current study showed that the qualitative and quantitative patterns of total metabolites could be discriminated by FT-IR spectrum analysis of whole-cell extracts of P. multiflorum root samples.
Conclusions
In this study, we optimized the culture conditions for P. multiflorum by carried out the experiments in sequence. The highest root biomass and bioactive compounds production were achieved on full-strength MS medium supplemented with 2 mg·L−1 IBA and 5% sucrose after 4 weeks of culture. Our results showed that FT-IR analysis can rapidly discriminate among root samples in various culture condition sources based on total metabolite equivalence. Overall, this study suggests that adventitious root cultures could be scaled up to provide materials for commercial purposes.
References
Baque MA, Lee EJ, Paek KY (2010) Medium salt strength induced changes in growth, physiology and secondary metabolite content in adventitious roots of Morinda citrifolia: the role of antioxidant enzymes and phenylalanine ammonia lyase. Plant Cell Rep 29:685–694
Baque MA, Moh SH, Lee EJ, Zhong JJ, Paek KY (2012) Production of biomass and useful compounds from adventitious roots of high-value added medicinal plants in bioreactor. Biotechnol Adv 30:1255–1267
Baque MD, Elgirban A, Lee EJ, Paek KY (2012) Sucrose regulated enhanced induction of anthraquinone, phenolics, flavonoids biosynthesis and activities of antioxidant enzymes in adventitious root suspension cultures of Morinda citrifolia (L.). Acta Physiol Plant 34:405–415
Baque MA, Shiragi MHK, Moh SH, Lee EJ, Paek KY (2013) Production of biomass and bioactive compounds by adventitious root suspension cultures of Morinda citrifolia (L.) in a liquid-phase airlift balloon-type bioreactor. Vitro Cell Dev Biol Plant 49:737–749
Bounda GA, Feng Y (2015) Review of clinical studies of Polygonum multiflorum Thunb. and its isolated bioactive compounds. Pharmacognosy Res 7:225–236
Chandra S, Chandra R (2011) Engineering secondary metabolite production in hairy roots. Phytochem Rev 10:371–395
Choi RY, Lee HI, Ham JR, Yee ST, Kang KY, Lee MK (2018) Heshouwu (Polygonum multiflorum Thunb.) ethanol extract suppresses pre-adipocytes differentiation in 3T3-L1 cells and adiposity in obese mice. Biomed Pharmacother 106:355–362
Cui XH, Chakrabarty D, Lee EJ, Paek KY (2010) Production of adventitious root biomass and secondary metabolites by Hypericum perforatum L. in a bioreactor. Bioresour Technol 101:4708–4716
Cui HY, Baque MA, Lee EJ, Paek KY (2013) Scale-up of adventitious root cultures of Echinacea angustifolia in a pilot-scale bioreactor for the production of biomass and caffeic acid derivatives. Plant Biotechnol Rep 7:297–208
Dai J, Mumper RJ (2010) Plant Phenolics: Extraction, analysis and their antioxidant and anticancer properties. Molecules 15:7313–7352
Fehér A (2019) Callus, dedifferentiation, totipotency, somatic embryogenesis: What term mean in the era of molecular plant biology? Front Plant Sci 10:536. https://doi.org/10.3389/fpls.2019.00536
Gamborg OL, Miller RA, Ojima K (1968) Nutrient requirements of suspension cultures of soybean root cells. Exp Cell Res 50:151–158
Ghimire BK, Kim HY, Seong ES, Yoo JH, Lee JH, Park SK, Kim SH, Yu CY, Chung IM (2018) Establishment of culturing conditions and assessment of antioxidant activity and somaclonal variation in the adventitious root suspension cultures of Oplopanax elatus Nakai. Acta Physiol Plant 40:52. https://doi.org/10.1007/s11738-018-2625-8
Han MN, Lu JM, Zhang GY, Yu J, Zhao RH (2015) Mechanistic studies on the use of Polygonum multiflorum for the treatment of hair graying. Biomed Res Int. https://doi.org/10.1155/2015/651048
Ho TT, Lee KJ, Lee JD, Bhushan S, Paek KY, Park SY (2017) Adventitious root culture of Polygonum multiflorum for phenolic compounds and its plot-scale production in 500 L-tank. Plant Cell Tiss Org Cult 130(1):167–181
Ho TT, Lee JD, Jeong CS, Paek KY, Park SY (2018) Improvement of biosynthesis and accumulation of bioactive compounds by elicitation in adventitious root cultures of Polygonum multiflorum. Appl Microbiol Biotechnol 102(1):199–209
Ho TT, Lee JD, Ahn MS, Kim SW, Park SY (2018) Enhanced production of phenolic compounds in hairy root cultures of Polygonum multiflorum and its metabolite discrimination using HPLC and FT-IR methods. Appl Microbiol Biotechnol 102:9563–9575
Ho TT, Murthy HN, Dalawai D, Bhat MA, Paek KY, Park SY (2019) Attributes of Polygonum multiflorum to transfigure red biotechnology. Appl Microbiol Biotechnol 103(8):3317–3326
Ho TT, Jeong CS, Lee H, Park S-Y (2019) Effect of explant type and genotype on the accumulation of bioactive compounds in adventitious root cultures of Polygonum multiflorum. Plant Cell Tiss Org Cult 137(1):115–124
Jeong CS, Murthy HN, Hahn EJ, Lee HL, Paek KY (2009) Inoculum size and auxin concentration influence the growth of adventitious roots and accumulation of ginsenosides in suspension cultures of ginseng (Panax ginseng C. A. Meyer). Acta Physiol Plant 31:219–222
Jiang YJ, Piao XC, Liu JS, Jiang J, Lian ZX, Kim MJ, Lian ML (2015) Bioactive compound production by adventitious root culture of Oplopanax elatus in balloon-type airlift bioreactor systems and bioactivity property. Plant Cell Tiss Org Cult 123:413–425
Jiang XL, Piao XC, Gao R, Jin MY, Jiang J, Jin XH, Lian ML (2017) Improvement of bioactive compound accumulation in adventitious root cultures of an endangered plant species. Oplopanax elatus Acta Physiol Plant 39:226. https://doi.org/10.1007/s11738-017-2525-3
Jiao J, Gai QY, Fu YJ, Ma W, Yao LP, Feng C, Xia XX (2015) Optimization of Astragalus membranaceus hairy roots induction and culture conditions for augmentation production of astragalosides. Plant Cell Tiss Org Cult 120:1117–1130
Kim YS, Hahn EJ, Paek KY (2004) Effects of various bioreactors on growth and ginsenoside accumulation in ginseng adventitious root cultures (Panax ginseng C.A. Meyer). Korean J Plant Biotechnol 31:249–253
Kim SW, Min SR, Kim JH, Park SK, Kim TI, Liu JR (2009) Rapid discrimination of commercial strawberry cultivars using Fourier transform infrared spectroscopy data combined by multivariate analysis. Plant Biotechnol Rep 3:87–93
Kim SW, Ahn MS, Kwon YK, Song SY, Kim JK, Ha SH, Kim IJ, Liu JR (2015) Monthly metabolic changes and PLS prediction of carotenoid content of citrus fruit by combined Fourier transform infrared spectroscopy and quantitative HPLC analysis. Plant Biotechnol Rep 9:247–258
Kwon YK, Ahn MS, Park JS, Liu JR, In DS, Min BW, Kim SW (2014) Discrimination of cultivation ages and cultivars of ginseng leaves using Fourier transform infrared spectroscopy combined with multivariate analysis. J Ginseng Res 38:52–58
Lee EJ, Paek KY (2012) Enhanced productivity of biomass and bioactive compounds through bioreactor cultures of Eleutherococcus koreanum Nakai adventitious root affected by medium salt strength. Ind Crop Prod 36:460–465
Lee EJ, Park SY, Paek KY (2015) Enhancement strategies of bioactive compound production in adventitious root cultures of Eleutherococcus koreanum Nakai subjected to methyl jasmonate and salicylic acid elicitation through airlift bioreactors. Pant Cell Tiss Organ Cult 120:1–10
Linsmaier EM, Skoog F (1965) Organic growth factor requirements of tobacco tissue cultures. Physiol Plant 18:100–127
Lishuang LV, Cheng YH, Zheng TS, Li XM, Zhai R (2014) Purification, antioxidant activity and antiglycation of polysaccharides from Polygonum multiflorum Thunb. Carbohyd Polym 99:765–773
Liu Y, Wang Q, Yang J, Guo X, Liu W, Ma S, Li S (2018) Polygonum multiflorum Thunb.: a review on chemical analysis, processing mechanism, quality evaluation, and hepatotoxicity. Front Pharmacol 9:1–16
Lulu T, Park SY, Ibrahim R, Paek KY (2015) Production of biomass and bioactive compounds from adventitious roots by optimization of culturing conditions of Ericoma longifolia in balloon-type bubble bioreactor system. J Biosci Bioeng 119:712–717
Martinez-Bonfil BP, Cruz-Hernandez A, Lopez-Laredo AR, Trejo-Tapia G, Trejo-Espino JL (2014) Effects of culture medium and auxins on growth of adventitious root cultures of Cuphea aequipetala Cav. and their ability to produce antioxidant compounds. Plant Cell Tiss Organ Cult 118:401–408
Murashige T, Skoog F (1962) A revised medium for rapid growth and bioassays with tobacco tissue cultures. Physiol Plant 15:473–479
Murthy HN, Dandin VS, Zhong JJ, Paek KY (2014) Strategies for enhanced production of plant secondary metabolites from cell and organ cultures. In: Paek KY, Murthy HN, Zhong JJ (eds) Production of biomass and bioactive compounds using bioreactor technology. Springer, Dordrecht, pp 471–508
Murthy HN, Dandin VS, Paek KY (2016) Tools for biotechnological production of useful phytochemicals from adventitious root cultures. Phytochem Rev 15:129–145
Nhut DT, Huy NP, Tai NT, Nam NB, Luan VQ, Hien VT, Tung HT, Binh BT, Luan TC (2015) Light-emitting diodes and their potential in callus growth, plantlet development and saponin accumulation during somatic embryogenesis of Panax vietnamensis Ha et Grushv. Biotechnol Biotec Eq 29:299–308
Paek KY, Murthy HN, Hahn EJ, Zhong JJ (2009) Large scale culture of ginseng adventitious roots for production of ginsenosides. Adv Biochem Eng Biotechnol 113:151–176
Park SY, Paek KY (2014) Bioreactor culture of shoots and somatic embryos of medicinal plants for production of bioactive compounds. In: Paek KY, Murthy HN, Zhong JJ (eds) Production of biomass and bioactive compounds using bioreactor technology. Springer, Dordrecht, pp 337–368
Praveen N, Murthy HN (2012) Synthesis of withanolide A depends on carbon source and medium pH in hairy root cultures of Withania somnifera. Ind Crops Prod 35:241–243
Schenk RU, Hildebrandt AC (1972) Medium and techniques for induction and growth of monocotyledonous and dicotyledonous plant cell cultures. Can J Bot 50:199–204
Schulz H, Baranska M (2007) Identification and quantification of valuable plant substances by IR and Raman spectroscopy. Vib Spectrosc 43:13–25
Shilpha J, Satish L, Kavikkuil M, Largia MJV, Ramesh M (2015) Methyl jasmonate elicits the solasodine production and anti-oxidant activity in hairy root cultures of Solanum trilobatum L. Ind Crop Prod 71:54–64
Song SY, Lee YK, Kim IJ (2016) Sugar and acid content of Citrus prediction modeling using FT-IR fingerprinting in combination with multivariate statistical analysis. Food Chem 190:1027–1032
Tam HT, Huong TT, Ngan HTM, Chien HX, Nam NB, Huy NP, Hien VT, Luan VQ, Cuong LK, Vinh BT, Luan TC, Ngoc PTB, Ha CH, Nhut DT (2013) Effects of IBA, NAA and IAA on regeneration and saponin accumulation of adventitious root of Panax vietnamensis Ha et Grushv. National Biotechnology Conference Proceedings, Hanoi, 1043–1048
Tam HT, Nam NB, Chien HX, Cuong LK, Tai NT, Cuong NV, Huy NP, Huong TT, Hieu T, Linh NTN, Nhut DT (2015) Optimization of culture conditions and medium composition for adventitious root induction from leaves of Panax vietnamensis Ha et Grushv. Vietnam J Biotechnol 13:865–873
Thanh NT, Murthy HN, Paek KY (2014) Optimization of ginseng cell culture in airlift bioreactors and developing the large-scale production system. Ind Crops Prod 60:343–348
Thiruvengadam M, Praveen N, Kim EH, Kim SH, Chung IM (2014) Production of anthraquinones, phenolic compounds and biological activities from hairy root cultures of Polygonum multiflorum Thunb. Protoplasma 251:555–566
Wu CH, Dewir YH, Hahn EJ, Paek KY (2006) Optimization of culturing conditions for the production of biomass and phenolics from adventitious roots of Echinacea angustifolia. J Plant Biol 49:193–199
Wu XQ, Chen XZ, Huang QC, Fang DM, Li GY, Zhang GL (2012) Toxicity of raw and processed roots of Polygonum multiflorum. Fitoterapia 3:469–475
Yoon YJ, Chung IM, Thiruvengadam M (2015) Evaluation of phenolic compounds, antioxidant and antimicrobial activities from transgenic hairy root cultures of gherkin (Cucumis anguria L.). S Afr J Bot 100:80–86
Yu KW, Hahn EJ, Paek KY (2000) Production of adventitious ginseng roots using bioreactors. Korean J Plant Tiss Cult 27:309–315
Zhang J, Gao WY, Wang J, Li XL (2012) Effects of sucrose concentration and exogenous hormones on growth and periplocin accumulation in adventitious roots of Periploca sepium Bunge. Acta Physiol Plant 34:1345–1351
Zhang B, Chen L, Huo Y, Zhang J, Zhu C, Zhang X, Ma Z (2020) Establishment of adventitious root cultures from leaf explants of Tripterygium wilfordii (thunder god vine) for the production of celastrol. Ind Crop Prod 155:112834. https://doi.org/10.1016/j.indcrop.2020.112834
Zhao Y, Guo WH, Sun XY, Li KH, Liu KJ, Wang J, Wang Y, Tan X, You XL (2020) A culture system for the stable and high-efficiency proliferation of adventitious roots of Panax notoginseng and ginsenoside accumulation. Ind Crop Prod 157:112882. https://doi.org/10.1016/j.indcrop.2020.112882
Acknowledgments
Authors were supported by Brain Korea (BK) 21 Plus Program through the National Research Foundation (NRF) of Korea.
Funding
This work was supported by the Korean Institute of Planning and Evaluation for Technology in Food, Agriculture, Forestry and Fisheries (IPET) through the Advanced Production Technology Development Program, funded by the Ministry of Agriculture, Food and Rural Affairs (MAFRA) (Grant Number 315013–4).
Author information
Authors and Affiliations
Contributions
Thanh-Tam Ho, Kim-Cuong Le contributed to data acquisition and manuscript writing. Suk-Weon Kim interpreted the data and revised the intellectual content. So-Young Park made substantial contributions to the conception and design of the study. All authors have read and agreed to the published version of the manuscript.
Corresponding author
Ethics declarations
Conflicts of interest
The authors declare no conflict of interest.
Additional information
Communicated by Wagner Campos Otoni.
Publisher's Note
Springer Nature remains neutral with regard to jurisdictional claims in published maps and institutional affiliations.
Electronic supplementary material
Below is the link to the electronic supplementary material.
Rights and permissions
About this article
Cite this article
Ho, TT., Le, KC., Kim, SW. et al. Culture condition optimization and FT-IR analysis of Polygonum multiflorum Thunb. adventitious root cultures grown in an air-lift bioreactor system. Plant Cell Tiss Organ Cult 144, 371–381 (2021). https://doi.org/10.1007/s11240-020-01961-9
Received:
Accepted:
Published:
Issue Date:
DOI: https://doi.org/10.1007/s11240-020-01961-9